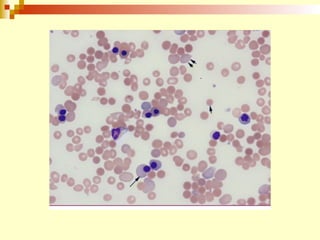
627674444.inmunohematología final

El documento proporciona una definición de la inmunohematología y describe varios aspectos clave de los grupos sanguíneos, incluidos los sistemas ABO, Rh y otros grupos. Explica la genética y antígenos involucrados en cada sistema, así como la importancia clínica de la detección y tipificación de los grupos sanguíneos.